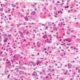
Tipos de células de la adenohipófisis

Localmente, las quemaduras causan necrosis por coagulación de la epidermis y los tejidos subyacentes y la profundidad de la lesión depende de la temperatura a la que se expuso la piel, el calor específico del agente causal y la duración de la exposición.
La profundidad de la quemadura varía en función del grado de lesión tisular. La profundidad se clasifica de acuerdo con el alcance de la lesión en la epidermis, la dermis, la grasa subcutánea y las estructuras subyacentes.
Las quemaduras de primer grado están limitadas a la epidermis. Son dolorosas, eritematosas, y palidecen al contacto, con una barrera epidérmica intacta. Estas quemaduras no dejan cicatrices y el tratamiento se centra en aliviar las molestias mediante lociones balsámicas, y fármacos antiinflamatorios no esteroideos orales. Ejemplo son quemaduras solares.
Las quemaduras de segundo grado tienen por definición cierto grado de afectación dérmica y su subdivisión depende de la profundidad de la lesión en la dermis. Se dividen en dos tipos:
- superficiales
- profundas.
Las quemaduras dérmicas superficiales son eritematosas, dolorosas, palidecen al contacto y a menudo forman ampollas. Ejemplos de estas lesiones son las escalda duras por el agua demasiado caliente. Estas heridas se reepitelizan espontáneamente a partir de estructuras epidérmicas mantenidas en crestas interpapilares, folículos pilosos y glándulas sudoríparas en una a dos semanas. Tras la cicatrización, es posible que presenten cambio de color cutáneo a largo plazo.
Las quemaduras dérmicas profundas, que alcanzan la dermis reticular, son más blanquecinas y moteadas, no palidecen al contacto, pero conservan la sensibilidad dolorosa al explorarlas con aguja. Curan en 2 a 5 semanas por reepitelización a partir de queratinocitos de folículos pilosos y glándulas sebáceas, a menudo con cicatrices importantes debidas a la ausencia de dermis.
Las quemaduras de tercer grado son lesiones que comprenden todo el espesor de la epidermis y la dermis, y se caracterizan por una escara dura y coriácea indolora y de color negro, blanco o rojo intenso. No queda ningún apéndice dérmico ni epidérmico; por tanto, estas quemaduras tienen que cicatrizar por reepitelización procedente de los bordes de la herida.
Las quemaduras dérmicas profundas y de todo el espesor requieren escisión e injertos de piel del propio paciente para curar las heridas en el momento apropiado.
Las quemaduras de cuarto grado afectan a otros órganos además de la piel, como músculo, hueso o cerebro. La determinación exacta de la profundidad es esencial para la cicatrización, dado que las quemaduras que curarán con tratamiento local se tratan de distinto modo que aquellas que precisan cirugía.

Fuente:
- Brunicardi C.F. Schwartz. Principios de cirugía. 11 ed. McGraw Hill. 2020